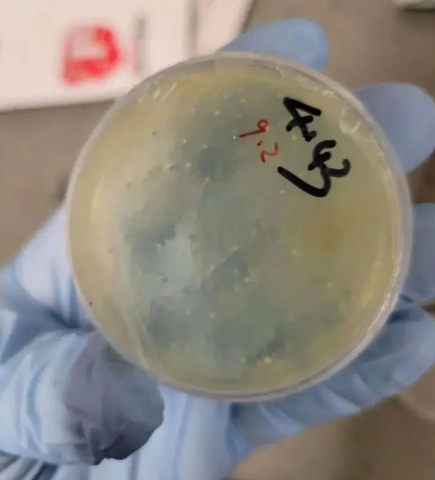

![]() |
| [뉴욕포스트 캡처] |
[헤럴드경제=나은정 기자] 농작물을 고사시키고 사람과 가축에 복통 등을 일으킬 수 있는 곰팡이를 미국에 밀반입하려던 중국 국적 연구원이 추방됐다. 미국 연방수사국(FBI)은 해당 사건을 공개하며 “학술 연구 명목으로 국가 안보를 위협하는 외국 세력의 시도를 단호히 막겠다”고 경고했다.
4일(현지시간) 뉴욕포스트에 따르면 미시간 대학교 연구원 지안(33)은 밀, 보리, 옥수수, 쌀 등 주요 작물에 치명적인 이삭마름병을 일으키는 병원성 곰팡이 ‘푸사리움 그라미네아룸’ 샘플을 사전 신고 없이 미국으로 들여오려다 지난 6월 공항에서 체포됐다.
이 곰팡이가 생성하는 독성 물질 ‘보미톡신’은 사람과 동물에게 복통, 구토, 발열 등을 유발하는 것으로 알려져 있으며, 미국 농업계에서는 매년 2억 달러(약 2938억원)~ 4억 달러(약 5876억원)의 피해가 발생하고 있다.
지안은 조사 과정에서 밀반입 사실을 은폐하기 위해 FBI 수사관에게 거짓 진술한 혐의도 인정했다. 검찰에 따르면 지안은 중국 공산당 당원 신분으로, 중국 정부로부터 연구 자금을 지원받고 있었다. 그와 함께 연구를 진행하던 남자친구 역시 같은 곰팡이를 배낭에 숨겨 들어오려다 공항에서 적발돼 입국을 거부당했다.
지안 측 변호인은 “정부가 사건을 과장했다”며 “해당 연구는 작물 보호 목적이었으며 악의적 의도는 없었다”고 주장했으나, 법원은 이를 받아들이지 않았다. 지안은 유죄 인정 직후 지난 2일(현지시각) 미국에서 추방됐다.
댄 본기노 FBI 부국장은 성명을 통해 “외국 정부가 미국의 연구 기관과 첨단 시설을 침투·악용하려는 시도는 점점 더 교묘해지고 있다”며 “국가 안보를 저해하는 행동에 대해서는 국적과 직책을 불문하고 엄중히 대응할 것”이라고 강조했다.